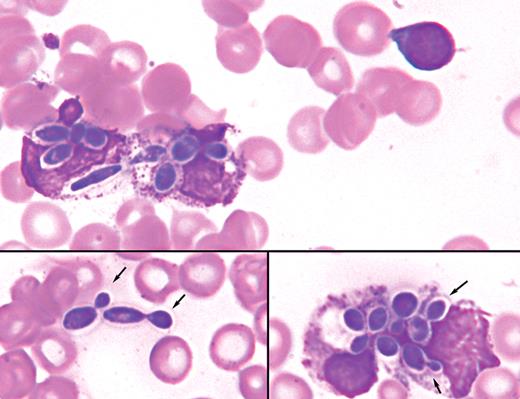
A 16-month-old boy with a history of chronic intestinal dysmotility requiring total parenteral nutrition was admitted with a suspected line-related sepsis. He had a leukocyte count of 4.3 × 109/L, hemoglobin 73 g/L, and platelets 43 × 109/L. Electrolytes, urea, creatinine, coagulation parameters, and liver function tests were all within normal ranges. On the peripheral blood smear, a microcytic anemia with thrombocytopenia was present along with intracellular and extracellular organisms (see figures), some with budding (arrows), in keeping with a fungal sepsis. Fluconazole was started empirically and subsequent blood cultures revealed Candida albicans as the causative agent 2 days later. / Candida species accounts for approximately 9% of hospital-acquired infections in the United States. Consequently, systemic fungal infections have become an important cause of morbidity and mortality, especially in the immunocompromised population. Timely diagnosis of fungemia has proven to be difficult as blood cultures often require 2 to 3 days of incubation. Although sensitivity of the peripheral smear review for yeast infection is low, in this case the peripheral blood smear led to the diagnosis of a blood-borne yeast infection before blood cultures became positive. In suspected patients, careful examination of a peripheral blood smear should be considered.

A 16-month-old boy with a history of chronic intestinal dysmotility requiring total parenteral nutrition was admitted with a suspected line-related sepsis. He had a leukocyte count of 4.3 × 109/L, hemoglobin 73 g/L, and platelets 43 × 109/L. Electrolytes, urea, creatinine, coagulation parameters, and liver function tests were all within normal ranges. On the peripheral blood smear, a microcytic anemia with thrombocytopenia was present along with intracellular and extracellular organisms (see figures), some with budding (arrows), in keeping with a fungal sepsis. Fluconazole was started empirically and subsequent blood cultures revealed Candida albicans as the causative agent 2 days later.
Candida species accounts for approximately 9% of hospital-acquired infections in the United States. Consequently, systemic fungal infections have become an important cause of morbidity and mortality, especially in the immunocompromised population. Timely diagnosis of fungemia has proven to be difficult as blood cultures often require 2 to 3 days of incubation. Although sensitivity of the peripheral smear review for yeast infection is low, in this case the peripheral blood smear led to the diagnosis of a blood-borne yeast infection before blood cultures became positive. In suspected patients, careful examination of a peripheral blood smear should be considered.
A 16-month-old boy with a history of chronic intestinal dysmotility requiring total parenteral nutrition was admitted with a suspected line-related sepsis. He had a leukocyte count of 4.3 × 109/L, hemoglobin 73 g/L, and platelets 43 × 109/L. Electrolytes, urea, creatinine, coagulation parameters, and liver function tests were all within normal ranges. On the peripheral blood smear, a microcytic anemia with thrombocytopenia was present along with intracellular and extracellular organisms (see figures), some with budding (arrows), in keeping with a fungal sepsis. Fluconazole was started empirically and subsequent blood cultures revealed Candida albicans as the causative agent 2 days later.
Candida species accounts for approximately 9% of hospital-acquired infections in the United States. Consequently, systemic fungal infections have become an important cause of morbidity and mortality, especially in the immunocompromised population. Timely diagnosis of fungemia has proven to be difficult as blood cultures often require 2 to 3 days of incubation. Although sensitivity of the peripheral smear review for yeast infection is low, in this case the peripheral blood smear led to the diagnosis of a blood-borne yeast infection before blood cultures became positive. In suspected patients, careful examination of a peripheral blood smear should be considered.
For additional images, visit the ASH IMAGE BANK, a reference and teaching tool that is continually updated with new atlas and case study images. For more information visit http://imagebank.hematology.org.